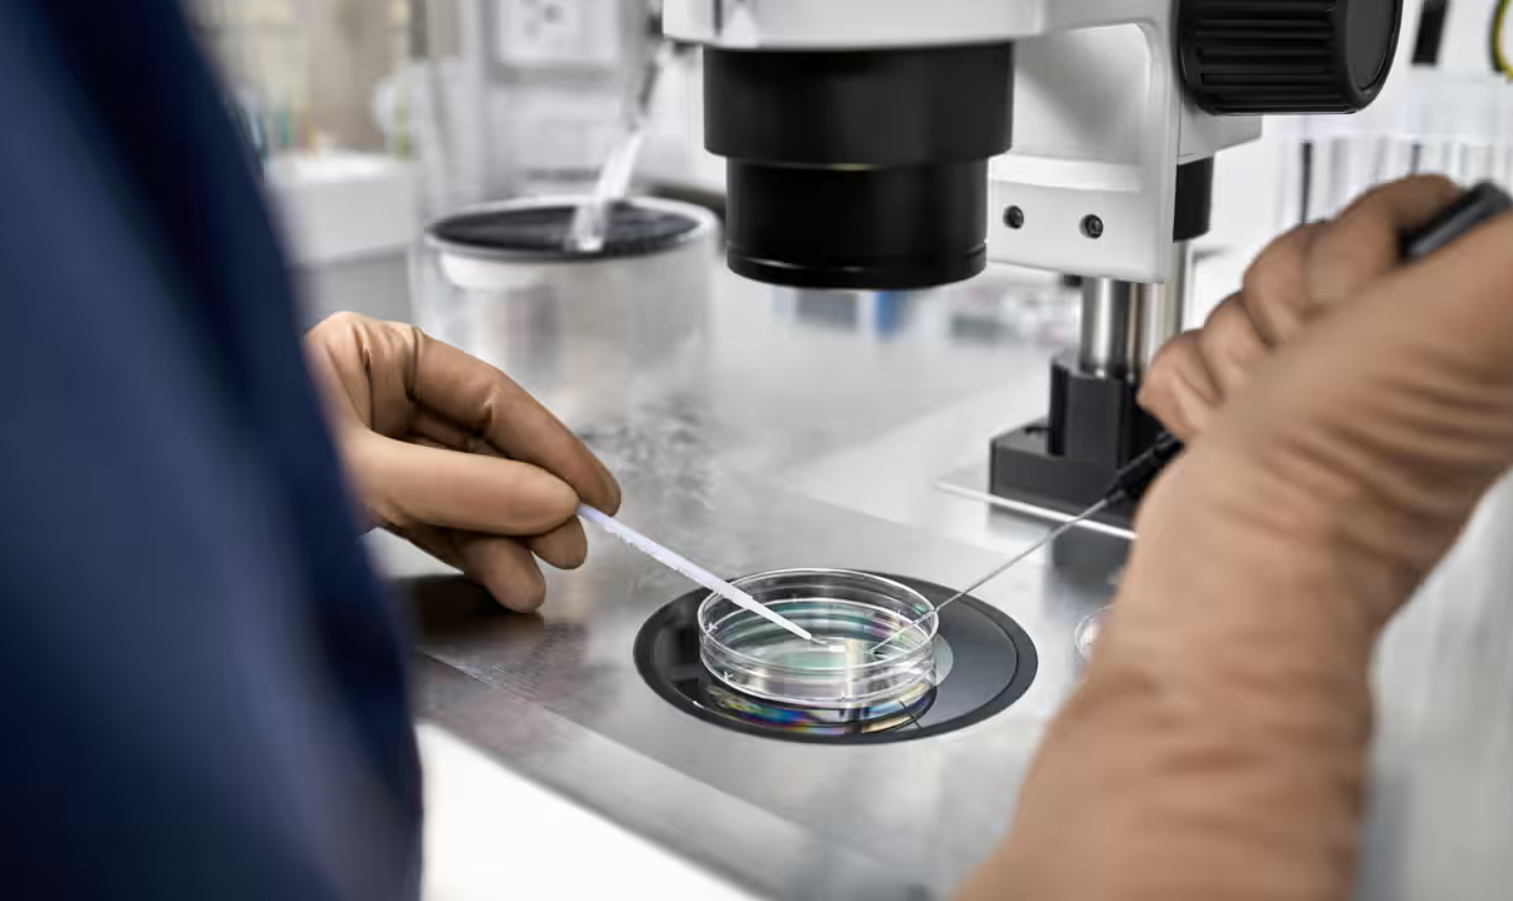
Công bố rúng động Hà Lan: Mỗi người hiến tinh trùng có thể làm cha hơn 25 đứa trẻ- Ảnh 1.

Tổ chức sản phụ khoa quốc gia (NVOG) cho biết, ít nhất 85 người hiến tinh trùng ở Hà Lan đã làm cha của 25 đứa con trở lên, sau khi một hệ thống đăng ký mới cho thấy các phòng khám hiếm muộn đã vi phạm các quy định hiện hành về hiến tinh trùng trong nhiều thập kỷ.
Theo thông tin từ NVOG công bố ngày 14/4, một số phòng khám hiếm muộn tại Hà Lan đã cố tình sử dụng các lô tinh trùng hơn 25 lần, trao đổi tinh trùng mà không có giấy tờ cần thiết hoặc không có sự đồng ý của người hiến tặng, và cho phép nhiều bệnh nhân tiếp nhận tinh trùng từ cùng một người hiến tặng tại nhiều phòng khám.
“Theo quy định, số lượng ‘người hiến tặng hàng loạt’ phải bằng 0”, bác sĩ phụ khoa Marieke Schoonenberg cho biết trên chương trình truyền hình Nieuwsuur. “Thay mặt cho toàn bộ ngành y tế, chúng tôi muốn xin lỗi. Chúng tôi đã không làm những việc mà họ đáng ra phải tuân thủ”.
(Ảnh: Alamy)
Một đạo luật nhằm mục đích giảm nguy cơ loạn luân không tự nguyện và hôn nhân cận huyết được ban hành tại Hà Lan kể từ năm 1992, giới hạn một người hiến tinh trùng chỉ được làm cha của tối đa 25 đứa trẻ, nhưng lại tỏ ra khó thực thi vì luật bảo mật nghiêm ngặt.
Giới hạn đã được hạ xuống còn 12 đứa trẻ vào năm 2018, nhưng các biện pháp để thực thi vẫn khó khăn. Cho đến đầu tháng 4/2025, hệ thống quản lý quốc gia với mã số riêng cho từng người hiến tinh trùng mới chính thức hoạt động. Nhờ đó, lần đầu tiên Hà Lan kiểm soát chính xác số trẻ em được sinh ra từ tinh trùng của một người là bao nhiêu.
“Kết quả là, lần đầu tiên chúng ta biết được số lượng trẻ em chính xác trên mỗi người hiến tặng”, bác sĩ Schoonenberg cho biết. Kể từ năm 2004, dữ liệu cho thấy đã có ít nhất 85 người hiến tặng hàng loạt (được định nghĩa là ít nhất 25 lần thụ thai) ở Hà Lan”, vị bác sĩ này tiết lộ.
Cũng theo bác sĩ Schoonenberg, một số người hiến tặng tinh trùng là cha ruột của từ 26 đến 40 đứa trẻ, một số thậm chí còn có từ 50 đến 75 đứa trẻ. Trong số đó có ít nhất 10 bác sĩ chuyên khoa sinh sản, bao gồm Jan Karbaat, người đã làm cha bất hợp pháp của ít nhất 81 đứa trẻ tại phòng khám của mình.
Người hiến tặng nhiều nhất là Jonathan Jacob Meijer, nhân vật chính trong bộ phim tài liệu The Man with 1,000 Kids của Netflix, người được biết là đã làm cha của ít nhất 550 đứa trẻ trên toàn thế giới. Hơn 100 đứa con của Meijer được thụ thai tại các phòng khám ở Hà Lan.

Một số phòng khám hiếm muộn đã vi phạm các quy định làm tăng nguy cơ di truyền ở một quốc gia nhỏ và tương đối đông dân như Hà Lan. (Ảnh minh họa)
Ông Ties van der Meer, chuyên gia của Stichting Donorkind, một tổ chức giúp trẻ em tìm kiếm cha là người hiến tặng tinh trùng, cho biết những phát hiện này là một “thảm họa y tế”. Ông cho biết dữ liệu đồng nghĩa với việc có ít nhất 3.000 trẻ em ở Hà Lan có 25 hoặc nhiều hơn anh chị em cùng cha khác mẹ.
Ông Van der Meer cho rằng tổn hại lớn nhất sự mất niềm tin vào hệ thống y tế, nhưng những điều này cũng chỉ là khởi đầu, bởi cả trẻ em và một số người hiến tặng chắc chắn sẽ phải chịu nhiều căng thẳng hơn.
Ông Van der Meer cho biết ở một quốc gia nhỏ, đông dân như Hà Lan, những đứa trẻ cùng huyết thống có khả năng gặp phải nhiều vấn đề thực tế hơn khi chúng lớn lên. “Một khi họ bắt đầu hẹn hò với ai đó, họ sẽ phải làm xét nghiệm DNA để đảm bảo rằng mình không hẹn hò với người thân”.
NVOG hiện đang kêu gọi các bà mẹ, người hiến tặng tinh trùng và trẻ em liên hệ với các phòng khám hiếm muộn của họ. Bộ Y tế Hà Lan cho biết họ sẽ thông báo tóm tắt với các đại biểu quốc hội về những phát hiện này trong tuần này.








